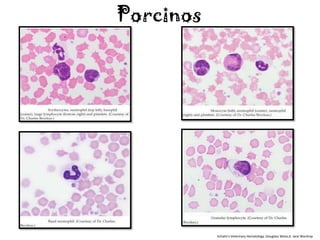
Porcinos




           Schalm's Veterinary Hematology ;Douglass Weiss,K. Jane Wardrop

El documento proporciona valores de referencia hematológicos para diferentes especies animales incluyendo caninos, felinos, equinos, bovinos, caprinos, ovinos, reptiles, aves y porcinos. Presenta datos como hematocrito, hemoglobina, recuento de eritrocitos, recuento de plaquetas, recuento de leucocitos y sus diferenciales, así como volumen corpuscular medio, contenido de hemoglobina corpuscular medio y concentración de hemoglobina corpuscular media.